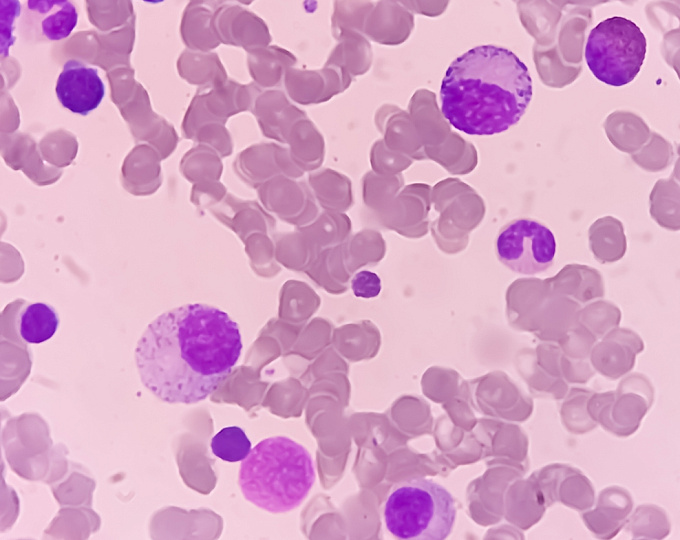
Локальная CAR-T терапия неходжкинских лимфом

Актуальность
Сегодня прогноз большинства пациентов с неходжкинскими лимфомами по-прежнему остается неблагоприятным. Одним из перспективных методов является CAR-T терапия. Однако ее применение сопряжено с трудностями изготовления и логистики клеточных продуктов.
В связи с чем целью данного исследования было изучение эффективности и безопасности локального изготовления CAR-T терапии в двух госпиталях США.
Методы
Исследование проводилось в двух клиниках США. Участниками были пациенты с рецидивирующими или рефрактерными CD+ неходжкинскими лимфомами, получившие ранее как минимум две линии системной терапии.
CAR-T клетки разрабатывались в госпиталях, занимающихся непосредственно лечением этих пациентов.
Результаты
В исследовании принял участие 31 пациент. Из них у 24 были агрессивные лимфомы, а у 7 – индолентные. Медиана числа предыдущих линий терапии составила 5.
Медиана от времени афереза до инфузии CAR-T составила 13 (9-13) дней. У 20 пациентов был зарегистрирован синдром выброса цитокинов. У 3-х он был 3-й стадии и тяжелее.
Оценка ответа на терапию была выполнена у 25 пациентов. Из них у 22 был полный ответ.
Медиана времени выживаемости без прогрессирования составила 26 месяцев
Заключение
Таким образом, первые результаты изучения локальной CAR-T терапии неходжкинских лимфом демонстрируют хорошую эффективность при возможности быстрой разработки клеточных продуктов.
Источник:
Armin Ghobadi, et al. The Lancet Discovery Science. 2025. Doi: 10.1016/j.eclinm.2025.103138